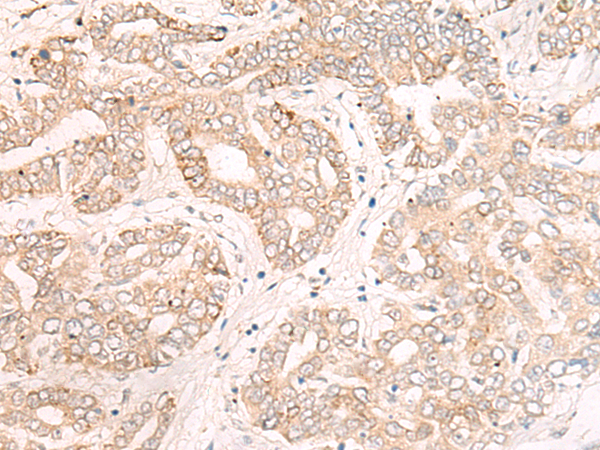

|
Background: |
This gene encodes a member of the plakin family of proteins that forms a component of desmosomes and the epidermal cornified envelope. This gene is located in the tylosis oesophageal cancer locus on chromosome 17q25, and its deletion is associated with both familial and sporadic forms of oesophageal squamous cell carcinoma. Patients suffering from the autoimmune mucocutaneous disorder, paraneoplastic pemphigus, develop antibodies against the encoded protein. |
|
Applications: |
ELISA, IHC |
|
Name of antibody: |
EVPL |
|
Immunogen: |
Synthetic peptide of human EVPL |
|
Full name: |
envoplakin |
|
Synonyms: |
EVPK |
|
SwissProt: |
Q92817 |
|
ELISA Recommended dilution: |
5000-10000 |
|
IHC positive control: |
Human liver cancer |
|
IHC Recommend dilution: |
25-100 |
購(gòu)物車(chē)
購(gòu)物車(chē) 幫助
幫助
 021-54845833/15800441009
021-54845833/15800441009
